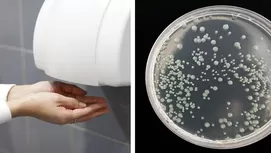
Descubre cómo desinfectar los trapos de tu cocina y dejarlos como nuevos

Descubre cómo desinfectar los trapos de tu cocina y dejarlos como nuevos
Estudios revelan que estos utensilios son potenciales transmisores de enfermedades, por ello sigue estas recomendaciones para desinfectar los trapos de cocina

Una cocina limpia es un lugar libre de bacterias y por ende, con un riesgo mínimo para el contagio de enfermedades. Pero, más importante que seguir pautas rigurosas de higiene, es fijarnos en las acciones más simples, como en el cambio y limpieza de los trapos de cocina.
Este utensilio comparte espacio no solo con otros objetos, sino que también tiene contacto con toda clase de alimentos diariamente, lo que la convierte en un foco infeccioso de gérmenes y distintos patógenos.
Un estudio de la Agencia de Protección Sanitaria británica (HPA) demostró que de 120 trapos de cocina analizados en establecimientos del Reino Unido, un 56% contenían diferentes bacterias como la E.coli, Staphylococcus, Listeria y enterobacterias.
Asimismo, otro estudio de la Universidad de Mauricio, presentado en la Sociedad Estadounidense de Microbiología, indicó una mayor presencia de bacterias Coliformes y Estafilococos áureos en el 49% de trapos, mientras más numerosa sea la familia.
Todas estas bacterias y gérmenes acumulados en los trapos de cocina, más aún si se mantienen húmedos, son causantes de diversas enfermedades: hepatitis, infecciones urinarias e intestinales, diarreas, cólera, poliomielitis, entre otras.
Cómo desinfectar trapos de cocina y otras recomendaciones
Y como no es suficiente lavar a diario los trapos usados en la cocina, aquí te dejamos una serie de recomendaciones:
- Separa los trapos que son para el secado de manos, manipulación de alimentos crudos y limpieza de vajillas o losetas.
- Mantén alejado aquellos paños con los que manipulas alimentos crudos del área de alimentos ya cocinado.
- Desinfecta los trapos con abundante jabón y lejía por lo menos tres veces por semana y dales una vida útil de no más de dos semanas.
- Procura utilizar trapos de algodón y sin muchas costuras para que no se acumule ninguna bacteria y no se propague a las manos u otros utensilios.
- Reemplaza su uso, de vez cuando, por paños de papel. No olvides ser amable con el medio ambiente.
Receta casera para que los trapos o manteles de tu cocina queden blancos y como nuevos
- Usa una olla, la más viejita que tengas.
- Llénala de agua y agrega un poco de lavavajillas con bicarbonato.
- Espera que hierva y agrega los trapos, manteles o secador de platos.
- Luego de unos minutos que hierva, notarás que tus manteles quedarán blancos y desinfectados
Recuerda, los trapos de cocina son muy prácticos, pero un mal uso podría significar la formación de microorganismos, que de llegar a los alimentos ocasionaría enfermedades críticas.